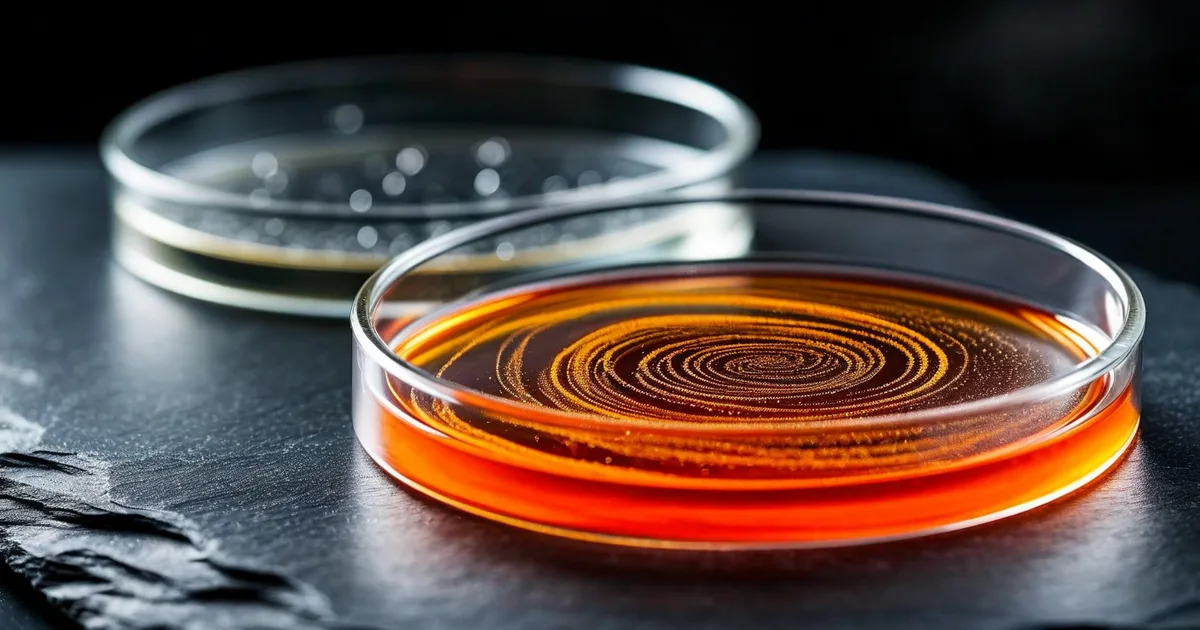
a b testing a proven methodology to optimize your web pages

📖
📖 BIMI Email Logo Display: Implementation Guide to Strengthen Brand Identity
Learn how to implement BIMI for email logo display. Step-by-step guide covering DNS, VMC certificates, and DMARC to boost brand recognition.
Read article →365 articles to master web, SEO and AI
 📖
📖 Learn how to implement BIMI for email logo display. Step-by-step guide covering DNS, VMC certificates, and DMARC to boost brand recognition.
Read article → ⚡
⚡ Discover how hot foil stamping and spot varnish transform ordinary print into luxury brand experiences. Techniques, costs, and expert tips inside.
Read article → 📖
📖 Learn how to set up Prestashop abandoned cart email sequences with proven templates, timing strategies, and automation tips to recover up to 15% of lost sales.
Read article → ⚡
⚡ Learn how Amazon S3 lifecycle policies automate data archiving and reduce cloud storage costs by up to 95%. Practical examples and implementation tips.
Read article → 📖
📖 Screen printing vs digital printing for custom textiles: compare costs, quality, durability, and production speed to choose the best method for your project.
Read article → 📖
📖 Master TikTok SEO in 2026 with proven strategies to rank your videos higher in TikTok search. Keywords, hashtags, captions & more.
Read article → ⚡
⚡ Learn how to use AMP for Email to add interactive forms and carousels to your campaigns. Boost engagement rates by up to 500% with dynamic email content.
Read article → 📖
📖 Learn how to write a creative brief that aligns teams, saves time, and delivers better design results. Includes templates, examples, and expert tips.
Read article → ⚡
⚡ Learn how to write a creative brief that ensures perfect deliverables. Templates, examples, and expert tips for structured project requests.
Read article → 📖
📖 Learn how to build a web acceptance testing plan with proven methodology, downloadable template, and expert tips for flawless project delivery.
Read article → 📖
📖 Learn how to optimize your product feeds for price comparison websites. Boost visibility, reduce errors, and increase e-commerce sales.
Read article → ⚡
⚡ Master food photography lighting and styling techniques to boost your restaurant's online presence. Practical tips for stunning menu visuals.
Read article → 📖
📖 Learn how to use Airtable for product catalog management. Step-by-step guide for SMBs with templates, examples, and no-code automation tips.
Read article → ⚡
⚡ Learn how to create and analyze custom conversion funnels in GA4. Step-by-step guide with practical examples to optimize your user journey.
Read article → ⚡
⚡ Is dropshipping still profitable in 2026? Discover the updated legal framework, logistics challenges, and real margins to expect.
Read article → 📖
📖 Discover how AWS Graviton ARM-based instances can reduce your cloud server costs by up to 40% while boosting performance. Migration guide included.
Read article → ⚡
⚡ Learn how to design effective vehicle wraps that last. Tips on materials, design principles, and ROI for durable advertising graphics.
Read article → 📖
📖 Master real estate photography with proven shooting techniques, editing workflows, and web optimization tips to sell properties faster online.
Read article → ⚡
⚡ Discover how Kanban boards help web teams visualize tasks, reduce bottlenecks, and deliver projects faster. Practical tips and examples included.
Read article → 📖
📖 Discover how vehicle wrapping transforms fleet branding in 2026. ROI data, materials, costs, and expert tips for maximum business visibility.
Read article → ⚡
⚡ Discover how drone and aerial photography can elevate your business visuals, boost engagement, and set your brand apart from the competition.
Read article → 📖
📖 Learn how DNSSEC protects domain name resolution from attacks in 2026. Complete guide with implementation steps, examples, and best practices.
Read article → ⚡
⚡ Learn how Drizzle ORM brings type-safe SQL queries to TypeScript with zero overhead. Practical examples, comparisons, and best practices.
Read article → 📖
📖 Discover how professional vehicle wraps can transform your fleet into mobile billboards. ROI, materials, design tips & cost breakdown included.
Read article → ⚡
⚡ Learn how to configure iOS Universal Links and Android App Links for seamless mobile deep linking. Step-by-step guide with code examples.
Read article → ⚡
⚡ Learn how to write a creative brief for web projects. Discover the ideal structure, real examples, and a ready-to-use template.
Read article → ⚡
⚡ Discover how small businesses use Airtable to automate sales management without coding. Practical tips, examples, and no-code workflows explained.
Read article → 📖
📖 Discover how Bubble empowers entrepreneurs and teams to build full web applications without code in 2026. Features, pricing, limits, and expert tips.
Read article → ⚡
⚡ Learn how to manage faceted navigation on Prestashop without creating duplicate content issues. Practical SEO strategies for e-commerce stores.
Read article → 📖
📖 Discover the key differences between free and paid stock photography. Learn how to choose the best web visuals for your website, budget, and brand.
Read article → ⚡
⚡ Discover best practices for web subcontracting between agencies: contracts, coordination tools, and tips to deliver projects on time and on budget.
Read article → 📖
📖 Learn how GeoDNS and DNS failover work together to guarantee website availability for international audiences. Practical examples and configurations included.
Read article → ⚡
⚡ Learn how to build a GA4 conversion funnel, identify drop-off points, and fix leaks that cost you revenue. Practical steps and real examples inside.
Read article → ⚡
⚡ Learn how to measure team velocity in web sprints, boost productivity with proven strategies, and deliver projects faster with agile best practices.
Read article → 📖
📖 Discover Drizzle ORM, the fast and lightweight TypeScript query builder. Learn setup, features, comparisons with Prisma, and best practices.
Read article → ⚡
⚡ Learn how to launch a LinkedIn newsletter in 2026 and grow a loyal B2B audience from zero. Strategy, tips, and real examples included.
Read article → 📖
📖 Learn how to make your PDF documents RGAA compliant. Practical guide with tools, code examples, and best practices for accessible PDFs.
Read article → ⚡
⚡ Discover the full RGAA accessibility audit methodology to make your website compliant and accessible by 2026. Step-by-step guide with practical tips.
Read article → 📖
📖 Learn how to choose and use royalty-free stock photos legally. Compare licenses, platforms, and best practices for web images.
Read article → ⚡
⚡ AI stock photos or professional shooting for your website in 2026? Compare costs, quality, SEO impact, and find the right visual strategy.
Read article → 📖
📖 Learn how to implement BIMI for your emails. Step-by-step guide covering DNS setup, VMC certificates, and logo display to boost brand trust and open rates.
Read article → ⚡
⚡ Learn how to manage multi-warehouse inventory on Prestashop with sync and automation. Practical guide with modules, tips, and best practices.
Read article → 📖
📖 Learn how faceted navigation creates duplicate content issues and discover proven SEO strategies to protect your online store's rankings.
Read article → ⚡
⚡ Learn how DNS configuration, propagation, and DNSSEC work in plain language. A practical guide for website owners and non-technical users.
Read article → 📖
📖 Learn how GeoDNS and DNS failover improve website performance by routing users to the nearest server. A complete guide to smart DNS traffic routing.
Read article → ⚡
⚡ Discover how Notion helps web agencies streamline project management in 2026 with efficient templates, automations, and collaborative workflows.
Read article → 📖
📖 Learn how to set up recurring payments and subscription management in Prestashop. Complete guide with modules, code examples, and best practices.
Read article → ⚡
⚡ Discover how HTMX lets you build interactive web apps without JavaScript in 2026. Faster, lighter, and simpler front-end development.
Read article →Learn how to set up GA4 custom events to track key user actions. Practical examples, code snippets, and best practices for better analytics.
Read article → ⚡
⚡ Discover how HTMX lets you build fast, dynamic web interfaces in 2026 without writing JavaScript. Lighter apps, faster delivery, better UX.
Read article → 📖
📖 Discover how Shape Up is replacing Scrum in web agencies. Compare methodologies, explore real examples, and learn how to implement Shape Up today.
Read article → ⚡
⚡ Discover how Airtable helps small businesses build custom databases without coding. Features, pricing, use cases, and expert tips included.
Read article → 📖
📖 Discover advanced email segmentation strategies that boost open rates, click-throughs, and conversions. Practical tips, examples, and code inside.
Read article → 📖
📖 Learn how variable fonts improve web performance, reduce load times, and elevate typography in 2026. Practical tips, code examples, and benchmarks.
Read article → ⚡
⚡ Learn how to set up server-side Google Tag Manager and discover its benefits for faster sites, better data accuracy, and improved privacy compliance.
Read article → 📖
📖 Flutter vs React Native in 2026: compare performance, ecosystem, and developer experience to choose the best cross-platform mobile framework.
Read article → ⚡
⚡ Learn how BIMI lets you display your brand logo in email inboxes, boost trust, and improve open rates. A complete guide to email authentication.
Read article → ⚡
⚡ Matomo vs Google Analytics 4 in 2026: compare privacy, features, cost, and accuracy to pick the best analytics platform for your website.
Read article → 📖
📖 Complete 2026 guide to vehicle wrap advertising: design best practices, installation techniques, costs, ROI, and the latest regulations you need to know.
Read article → ⚡
⚡ Learn how to achieve RGAA web accessibility compliance. Practical audit guide for public and private websites with actionable steps and key criteria.
Read article → 📖
📖 Discover the 5-email welcome sequence that converts new subscribers into loyal customers. Templates, timing, and proven strategies inside.
Read article → ⚡
⚡ Learn how to warm up a new email IP address step by step. Build sender reputation, avoid spam folders, and maximize deliverability from day one.
Read article → 📖
📖 Learn how to create stunning 360-degree product packshots. Complete technical guide covering equipment, software, coding, and best practices.
Read article → ⚡
⚡ Discover how to choose the best multi-touch attribution model in GA4 for your e-commerce store. Compare data-driven, linear, and more.
Read article → 📖
📖 Master mobile deep linking to seamlessly connect your website and app. Learn types, implementation, and best practices in this complete guide.
Read article → ⚡
⚡ Discover how hot foil stamping and premium print finishes can transform your brand materials. Tips, techniques, and real-world examples inside.
Read article → ⚡
⚡ Discover how multi-touch attribution reveals every touchpoint in the customer journey before purchase. Models, examples, and actionable insights.
Read article → 📖
📖 Master the web project brief in 2026. Get a complete template, real examples, and learn the costly mistakes to avoid before launching your next project.
Read article → ⚡
⚡ Learn how mobile deep linking improves user experience, boosts conversions, and drives app engagement. A practical guide with examples and best practices.
Read article → 📖
📖 Learn how to set up SPF, DKIM and DMARC step by step to boost your email deliverability and protect your domain from spoofing.
Read article → ⚡
⚡ Learn how Planning Poker and Agile estimation techniques help you accurately scope web projects, reduce risk, and deliver on time and budget.
Read article → 📖
📖 Discover how AI is reshaping web development, SEO, and coding. Expert insights, tools, and strategies to future-proof your digital presence.
Read article → 📖
📖 Complete AWS SMB cloud guide covering hosting, Lambda serverless, migration & pricing. Expert tips to scale your small business on AWS.
Read article → 📖
📖 Master every step of building a professional website in 2026. Costs, planning, design, tech stack & launch checklist included.
Read article → 📖
📖 Master Core Web Vitals optimization with our expert guide. Improve LCP, FID, CLS & INP scores to boost SEO rankings and user experience.
Read article → 📖
📖 Your ultimate launch online store guide for 2026. Step-by-step strategies, platform comparisons, and expert tips to start selling online successfully.
Read article → 📖
📖 Master Generative Engine Optimization (GEO) with our expert guide. Learn how to rank in AI search engines like ChatGPT & Perplexity.
Read article → 📖
📖 Learn how to choose a web agency with confidence. Expert criteria, real pricing data, RFP templates & red flags to avoid costly mistakes.
Read article → 📖
📖 PrestaShop vs Shopify vs WooCommerce — features, pricing, performance & scalability compared. Find your ideal ecommerce platform in 2026.
Read article → 📖
📖 Master SEO in 2026 with our definitive guide. Strategies, technical tips & expert insights to dominate search rankings. Start optimizing now.
Read article → 📖
📖 The ultimate website security guide for 2026. Learn how to prevent hacking, implement SSL, WAF & GDPR compliance. Actionable expert tips inside.
Read article → 📖
📖 Discover how the right to be forgotten and delisting impact businesses in 2026. Practical steps, legal frameworks, and compliance strategies explained.
Read article → ⚡
⚡ Learn how to set up a GDPR-compliant Consent Management Platform (CMP) in 2026. Practical steps, tools, and legal requirements explained.
Read article → 📖
📖 Discover how the 2025 RGAA web accessibility law affects small businesses. Practical compliance guide with checklists, deadlines, and expert tips.
Read article → 📖
📖 Discover the critical clauses in SaaS and cloud contracts your business must review. Protect your data, uptime, and budget with our expert guide.
Read article → ⚡
⚡ Discover what legal notices your website needs, from privacy policies to cookie consent. A complete compliance guide to avoid fines.
Read article → ⚡
⚡ E-invoicing becomes mandatory in 2026. Learn how to prepare your e-commerce site for compliance with France's new electronic invoicing regulation.
Read article → ⚡
⚡ Learn how to write compliant e-commerce terms and conditions in 2026. Key legal requirements, GDPR updates, and practical tips for online stores.
Read article → ⚡
⚡ Learn how AWS Auto Scaling dynamically adjusts server capacity to handle traffic spikes, cut costs, and maintain performance for your website.
Read article → 📖
📖 Learn how CDN and edge computing can drastically speed up your website delivery in France. Practical tips, benchmarks, and expert configuration advice.
Read article → ⚡
⚡ Learn how Git hooks and CI/CD pipelines automate code quality checks before deployment. Practical examples, tools, and best practices for dev teams.
Read article → ⚡
⚡ Stripe vs PayPlug vs Mollie: discover which payment gateway fits your SMB best. Compare fees, features, and integrations for e-commerce success.
Read article → ⚡
⚡ Learn how to build effective brand guidelines that ensure consistency. Discover key components, real examples, and expert tips for your brand book.
Read article → ⚡
⚡ Discover how a CDN speeds up your website globally by caching content closer to users. Learn benefits, key metrics, and how to implement one.
Read article → ⚡
⚡ Discover how chatbots and messaging apps are transforming conversational marketing in 2026. Boost conversions with AI-driven customer engagement strategies.
Read article → ⚡
⚡ The EU Cyber Resilience Act takes effect in 2026. Learn what it means for web developers, digital publishers, and how to prepare your projects now.
Read article → ⚡
⚡ Learn how to sync PrestaShop with your warehouse for real-time inventory management. Reduce stockouts, overselling, and manual errors.
Read article → ⚡
⚡ Discover how to optimize e-commerce returns management and reverse logistics in 2026. Reduce costs, boost loyalty, and streamline operations.
Read article → 📖
📖 Discover how Google Gemini 2.5 Pro transforms web development with advanced coding, debugging, and AI-assisted workflows for developers.
Read article → ⚡
⚡ Discover how one-click checkout slashes cart abandonment rates in 2026. Learn implementation tips, stats, and best practices for your online store.
Read article → 📖
📖 Discover how AWS Graviton4 processors can slash your web hosting costs by up to 40%. Benchmarks, migration tips, and real-world savings explained.
Read article → 📖
📖 Discover when and how to use AWS S3 Express One Zone in 2026. Performance benchmarks, cost analysis, use cases, and implementation guide.
Read article → 📖
📖 Discover how small and medium businesses can use Claude 4 and GPT-5 to boost productivity, cut costs, and compete with larger companies in 2026.
Read article → 📖
📖 Discover proven email newsletter strategies for 2026 that bypass AI-powered spam filters and boost deliverability, open rates, and conversions.
Read article → 📖
📖 Practical EU AI Act compliance guide for websites and e-commerce stores. Risk categories, timelines, and actionable steps to stay legal.
Read article → ⚡
⚡ Learn how to configure Google Analytics 4 with Consent Mode V2 in 2026. Practical steps, data modeling tips, and compliance best practices.
Read article → ⚡
⚡ Google's March 2026 core update shakes rankings. Discover what changed, who's impacted, and our expert SEO action plan to recover fast.
Read article → ⚡
⚡ Discover how online sensory branding uses sound, touch, and emotion to create memorable digital experiences that go far beyond visual design.
Read article → ⚡
⚡ Discover PrestaShop 9's major new features, performance gains, and our step-by-step migration guide to upgrade your store in 2026.
Read article → ⚡
⚡ Discover how social commerce is transforming e-commerce in 2026. Learn to sell directly on Instagram, TikTok, and Pinterest with proven strategies.
Read article → ⚡
⚡ Discover proven SSR best practices with Next.js to boost performance, improve SEO, and deliver faster web experiences. Practical tips and examples inside.
Read article → ⚡
⚡ Discover how AI is reshaping marketing personalization in 2026. Learn hyper-targeting strategies, real-world examples, and key trends to boost ROI.
Read article → ⚡
⚡ Learn what INP (Interaction to Next Paint) is, why it replaced FID as a Core Web Vital, and how to optimize it for better UX and SEO in 2025.
Read article → 📖
📖 Learn what AI hallucinations are, why they happen, and proven strategies to detect and prevent them in production AI systems.
Read article → ⚡
⚡ Master email deliverability in 2026 with DMARC, BIMI, and new sender rules. Practical guide with concrete steps to reach the inbox.
Read article → ⚡
⚡ Learn how AVIF, WebP, and lazy loading can cut page load times by 50%+ in 2026. Practical tips, format comparisons, and implementation guides.
Read article → ⚡
⚡ Discover how Google SGE is reshaping SEO and learn actionable strategies to maintain visibility in AI-powered search results.
Read article → ⚡
⚡ Learn how tree shaking, code splitting, and bundle optimization can cut your JavaScript payload by up to 70% and boost web performance.
Read article → ⚡
⚡ Discover why marketing automation and CRM are must-have tools for SMBs in 2026. Boost leads, sales, and retention with the right strategy.
Read article → ⚡
⚡ Learn how to combine HTTP caching and Service Workers to build an ultra-fast website. Practical strategies, code examples, and performance tips.
Read article → ⚡
⚡ Learn how to build a powerful backlink strategy that boosts your SEO rankings. Proven netlinking tactics, examples, and expert tips for lasting results.
Read article → 📖
📖 Discover how ChatGPT ads reshape digital marketing in 2026. Strategies, impacts on SEO, budgets, and what brands need to know now.
Read article → ⚡
⚡ Learn proven YouTube SEO strategies to rank your videos higher, drive more views, and maximize visibility. Actionable tips from web experts.
Read article → ⚡
⚡ Discover proven UX design principles that turn visitors into customers. Learn actionable tips to boost conversions on your website.
Read article → ⚡
⚡ Discover essential WordPress security tips for 2025. Protect your site from hackers with our expert guide covering plugins, firewalls, and best practices.
Read article → ⚡
⚡ Discover proven SEO strategies for Prestashop stores. Boost organic traffic, improve rankings, and increase e-commerce sales with actionable tips.
Read article → ⚡
⚡ Discover what Jamstack is, how it works, and why it's revolutionizing modern web development. A clear, practical guide with real-world examples.
Read article → ⚡
⚡ Learn how to optimize WordPress speed with proven techniques. From caching to image compression, boost your Core Web Vitals and rankings.
Read article → ⚡
⚡ Learn how to build a multilingual website with our technical guide covering hreflang, URL structures, CMS setup, and i18n best practices.
Read article → ⚡
⚡ Learn how to build a solid web disaster recovery plan to minimize downtime, protect data, and restore your website fast after any incident.
Read article → 📖
📖 Discover how Web3 and blockchain are reshaping web development in 2025. Concrete examples, code, and expert insights on decentralized websites.
Read article → ⚡
⚡ Learn how to build a design system with a cohesive UI component library. Practical tips, real examples, and expert advice for scalable web design.
Read article → 📖
📖 Learn how to deploy LLMs in production with scalable, reliable architecture. Practical guide with code examples, patterns, and cost strategies.
Read article → 📖
📖 Learn how to achieve PCI DSS compliance for your e-commerce store in 2025. Requirements, levels, checklist, and expert tips for online merchants.
Read article → ⚡
⚡ Learn how to optimize your website for voice search and AI assistants. Practical tips, concrete examples, and SEO strategies for 2025.
Read article → ⚡
⚡ Learn how responsive design and mobile-first development ensure your website performs on every device. Tips, stats, and best practices inside.
Read article → ⚡
⚡ Discover proven local SEO strategies for SMBs and artisans. Dominate your geographic zone with Google Business, citations, and local content.
Read article → ⚡
⚡ Learn how to measure your website speed with the right tools and understand Core Web Vitals, TTFB, and other critical performance metrics.
Read article → 📖
📖 PaaS vs IaaS explained: compare costs, control, scalability, and use cases to choose the best cloud hosting solution for your web project.
Read article → ⚡
⚡ Learn why HTTPS and SSL certificates are essential for website security in 2025. Practical guide with tips, stats, and best practices.
Read article → 📖
📖 Explore SSR, SSG, and ISR rendering patterns. Learn how each impacts web performance, SEO, and user experience with concrete examples and benchmarks.
Read article → ⚡
⚡ Explore the ethical challenges of AI in web development and discover best practices to build fair, transparent, and responsible digital experiences.
Read article → ⚡
⚡ Discover essential AWS IAM security best practices to protect your cloud infrastructure. Actionable tips, real examples, and expert guidance.
Read article → ⚡
⚡ Learn how to set up and use Google Analytics 4 (GA4) from scratch. A beginner-friendly guide covering events, reports, and key metrics.
Read article → ⚡
⚡ Learn how WordPress Multisite lets you manage multiple websites from one dashboard. Setup, pros, cons, and best practices explained.
Read article → ⚡
⚡ Discover how long-tail keywords drive higher conversion rates in B2B SEO. Concrete strategies, real examples, and expert tips to boost qualified leads.
Read article → 📖
📖 Learn how to build a powerful digital brand identity online. Expert tips on logo, color, typography, and consistency for lasting impact.
Read article → ⚡
⚡ Discover proven strategies to speed up your Prestashop store. Boost load times, conversions, and SEO with these expert performance tips.
Read article → 📖
📖 Learn how to build automated reports with Looker Studio and GA4 in 2025. Step-by-step guide with templates, tips, and best practices.
Read article → ⚡
⚡ Learn how to implement AI chatbots on your website. Step-by-step guide covering tools, best practices, and ROI tips for smarter customer engagement.
Read article → ⚡
⚡ Learn how to design a robust REST API with proven architecture patterns and best practices. Practical examples, naming conventions, and security tips.
Read article → ⚡
⚡ Discover how AI is revolutionizing branding — from logo design to brand strategy. Learn how artificial intelligence transforms brand creation in 2025.
Read article → 📖
📖 Learn how DNS propagation works, explore key DNS records (A, CNAME, MX, TXT), and avoid common hosting mistakes. A complete guide.
Read article → ⚡
⚡ Learn how web accessibility and inclusive design improve UX, boost SEO, and expand your audience. Practical tips and WCAG guidelines explained.
Read article → 📖
📖 Discover Deno and Bun, the JavaScript runtimes challenging Node.js in 2025. Features, benchmarks, comparisons, and expert guidance.
Read article → 📖
📖 Learn how to protect your website from ransomware in 2025. Expert prevention strategies, response plans, and real-world examples to keep your business safe.
Read article → ⚡
⚡ Discover practical strategies for eco-friendly graphic design that reduce print's environmental footprint without sacrificing quality or creativity.
Read article → ⚡
⚡ Discover how AI fine-tuning transforms generic models into powerful business tools. Learn methods, benefits, and real-world examples.
Read article →Discover how server-side tracking replaces third-party cookies for accurate analytics, better privacy compliance, and improved website performance.
Read article → ⚡
⚡ Discover the best Git workflows and practices for development teams. Compare Git Flow, GitHub Flow, and trunk-based development to boost productivity.
Read article → ⚡
⚡ Discover how Figma transforms web design workflows with real-time collaboration, reusable components, and faster prototyping. Tips and best practices inside.
Read article → 📖
📖 Discover how HTTP/3 and QUIC are revolutionizing web performance in 2025. Faster connections, reduced latency, and better security explained.
Read article → ⚡
⚡ Discover the complete 2025 checklist to secure your Linux server. SSH hardening, firewall, updates, and more — protect your infrastructure today.
Read article → 📖
📖 Compare Jest, Vitest, and Testing Library for JavaScript testing in 2025. Setup guides, benchmarks, code examples, and best practices.
Read article → ⚡
⚡ Discover how internal linking can dramatically improve your SEO rankings, user experience, and organic traffic. A complete guide with actionable tips.
Read article → ⚡
⚡ Learn how to develop a professional WordPress plugin from scratch. Best practices, code examples, and expert tips for clean, scalable plugin development.
Read article → ⚡
⚡ Discover how AWS Bedrock lets you integrate generative AI into your apps without managing infrastructure. Models, use cases, and practical guide.
Read article → 📖
📖 Learn how to go from wireframe to interactive prototype using Figma. Step-by-step guide with tips, examples, and best practices for rapid prototyping.
Read article → ⚡
⚡ Discover why Astro is the go-to framework for building fast, SEO-optimized static websites. Complete analysis by Lueur Externe.
Read article → ⚡
⚡ Discover how automated testing ensures web application quality, reduces bugs by up to 80%, and accelerates delivery. Practical guide with examples.
Read article → ⚡
⚡ Discover how web penetration testing helps identify vulnerabilities before hackers do. Learn key methods, tools, and why pentesting matters.
Read article → 📖
📖 AWS Bedrock vs OpenAI: in-depth comparison of pricing, models, security, and scalability. Find the best AI platform for your dev projects.
Read article → ⚡
⚡ Discover how AI image generators like Midjourney, DALL-E, and Adobe Firefly are transforming brand visuals. Compare features, pricing, and use cases.
Read article → ⚡
⚡ Discover how Google SGE (Search Generative Experience) is reshaping SEO strategies. Learn what changes and how to adapt your content.
Read article → 📖
📖 Learn how cohort analysis helps you understand visitor retention, reduce churn, and boost conversions. A practical guide with examples and code.
Read article → ⚡
⚡ Discover how emotional design transforms websites into memorable experiences. Practical tips, real examples, and 2025 trends to boost engagement.
Read article → ⚡
⚡ Discover our proven 7-step SEO audit methodology. Learn how to diagnose issues, fix errors, and improve your search rankings effectively.
Read article → ⚡
⚡ Discover the latest CSS features in 2025: CSS Grid, Container Queries, and more. Learn how modern CSS transforms front-end development.
Read article → ⚡
⚡ Protect your website against cyber threats. Essential web security best practices guide by Lueur Externe, expert web agency.
Read article → ⚡
⚡ Learn how to optimize your website for generative AI and LLM responses. Practical SEO strategies to stay visible in the age of ChatGPT and AI search.
Read article → ⚡
⚡ Discover the ultimate technical SEO checklist for 2025. Core Web Vitals, crawlability, structured data, and more to boost your rankings.
Read article → ⚡
⚡ Chatbot or contact form? Discover which conversion tool drives more leads, with real data, comparisons, and expert tips to choose the right one.
Read article → 📖
📖 Learn how to configure Content Security Policy (CSP) headers to protect your website from XSS, data injection, and other threats. Practical guide with examples.
Read article → ⚡
⚡ Discover why Laravel is the go-to PHP framework for custom web projects. Explore its advantages, real-world use cases, and how it accelerates development.
Read article → ⚡
⚡ Learn how to build high-performing email newsletters that boost engagement and drive conversions. Proven tips, examples, and key metrics inside.
Read article → ⚡
⚡ Discover why TypeScript is the go-to language for web development in 2025. Fewer bugs, better scalability, and stronger teams. Learn the key benefits.
Read article → ⚡
⚡ Discover how artificial intelligence is reshaping digital marketing in 2025. Explore key trends, practical tools, and strategies to stay ahead.
Read article → ⚡
⚡ Learn how to create reusable Web Components using native browser APIs. No framework needed — just HTML, CSS, and JavaScript.
Read article → ⚡
⚡ Discover the specific hosting requirements for PrestaShop and WooCommerce. Compare PHP, RAM, database needs and choose the right setup.
Read article → ⚡
⚡ Discover advanced web performance optimization techniques for 2025. Core Web Vitals, image formats, edge computing, and more.
Read article →Learn how to set up advanced GA4 e-commerce tracking on PrestaShop. Step-by-step guide covering data layers, events, and revenue attribution.
Read article → 📖
📖 Master prompt engineering for web projects. Learn proven techniques, examples, and frameworks to write AI prompts that deliver real results.
Read article → ⚡
⚡ Learn how to build a headless WordPress site using the REST API and Next.js for blazing-fast performance and modern frontend flexibility.
Read article → ⚡
⚡ Learn how to develop a custom WordPress theme from scratch. Key steps, best practices, performance tips, and why bespoke themes outperform generic ones.
Read article → 📖
📖 Learn how to win featured snippets and claim Google's position zero. Proven strategies, real examples, and structured data tips to boost your SEO.
Read article → ⚡
⚡ Learn how schema markup and structured data boost your SEO rankings, click-through rates, and visibility in search results. A practical guide.
Read article → ⚡
⚡ Discover essential PrestaShop security best practices to protect your online store from hackers, malware, and data breaches. Actionable tips inside.
Read article → 📖
📖 Discover our complete website maintenance checklist with monthly and annual tasks to keep your site secure, fast, and SEO-optimized.
Read article → ⚡
⚡ Master Core Web Vitals in 2025 with actionable tips on LCP, INP, and CLS. Boost your site speed, UX, and Google rankings today.
Read article → ⚡
⚡ Discover why Node.js is the go-to runtime for building fast, scalable backend APIs. Architecture tips, benchmarks, and real-world examples included.
Read article → 📖
📖 Learn why a company blog is essential in 2025 and how to create one that drives traffic, builds authority, and converts visitors into customers.
Read article → 📖
📖 Discover why outsourcing server management saves time, money, and headaches. Learn the benefits of web managed hosting for your business.
Read article → ⚡
⚡ Learn how to migrate from WordPress to a headless CMS step by step. Boost performance, security, and flexibility with this practical guide.
Read article →Learn how to create, optimize, and implement SVG icons for modern websites. Boost performance, scalability, and design consistency.
Read article → ⚡
⚡ Learn how to run a web performance audit using Lighthouse and WebPageTest. Step-by-step methodology, key metrics, and actionable optimization tips.
Read article → 📖
📖 Learn how to use Google Search Console to analyze organic search data, boost rankings, and optimize your SEO strategy with actionable tips.
Read article → ⚡
⚡ Are autonomous AI agents a genuine technological breakthrough or overhyped trend? Explore real use cases, market data, and what it means for your business.
Read article → 📖
📖 Learn how to build custom Gutenberg blocks with ACF Pro for WordPress. Code examples, best practices, and performance tips from expert developers.
Read article → ⚡
⚡ The latest trends in web design for 2025: performance, accessibility, and optimal user experience for modern websites.
Read article → ⚡
⚡ Discover the top graphic design trends for 2025 — from bold color palettes and expressive typography to AI-driven styles reshaping the creative landscape.
Read article → ⚡
⚡ Discover the best server monitoring tools and alert strategies to prevent downtime and keep your infrastructure running smoothly. Expert tips inside.
Read article → ⚡
⚡ Learn how to craft high-converting Prestashop product descriptions with proven SEO techniques, real examples, and actionable tips.
Read article → ⚡
⚡ Build an effective SEO content strategy in 2025. Keyword research, editorial planning, and optimization techniques by Lueur Externe.
Read article → ⚡
⚡ Learn how to optimize your content for language models and improve your visibility in AI-generated responses.
Read article → ⚡
⚡ Learn how A/B testing can boost conversions by up to 49%. Discover a step-by-step methodology to optimize your web pages effectively.
Read article → ⚡
⚡ Can a one-page website rank on Google in 2025? Discover the real SEO challenges, smart workarounds, and expert strategies for single-page sites.
Read article → ⚡
⚡ Learn how to conduct a brand audit to evaluate perception, image consistency, and market positioning. Actionable steps and real-world examples inside.
Read article → 📖
📖 Explore the evolving landscape of generative AI copyright law in 2025. Key rulings, global regulations, and practical guidance for businesses.
Read article → 📖
📖 Discover everything about managed WordPress hosting: advantages, drawbacks, pricing, and how to choose the right provider for your site.
Read article → 📖
📖 Learn how to detect SEO cannibalization, understand why keyword conflicts hurt rankings, and apply proven fixes to reclaim lost organic traffic.
Read article → ⚡
⚡ Learn how to secure your REST API in 2025 with JWT, OAuth 2.0, rate limiting, and proven best practices to protect your data and users.
Read article → ⚡
⚡ Discover how a headless CMS decouples front-end from back-end to boost flexibility, performance, and scalability. A complete guide with examples.
Read article → ⚡
⚡ Master CSS animations and web motion design in 2025. Practical tips, code examples, and performance best practices for modern websites.
Read article → 📖
📖 Learn how to repurpose a single blog post into 10 high-performing content formats. Save time, boost SEO, and maximize your reach with content recycling.
Read article → ⚡
⚡ Discover actionable personal branding strategies for freelancers and web agencies. Build trust, attract clients, and stand out in a crowded digital market.
Read article → ⚡
⚡ Learn the key requirements and best practices for video subtitling and accessibility. Boost engagement, SEO, and compliance with our expert guide.
Read article → 📖
📖 Learn how to run website analytics in full GDPR compliance. Practical tips, tool comparisons, and code examples for privacy-first data collection.
Read article → ⚡
⚡ Learn how preload, prefetch, and preconnect resource hints can dramatically improve your website loading speed and Core Web Vitals scores.
Read article → ⚡
⚡ Discover how RAG (Retrieval-Augmented Generation) and knowledge bases transform AI apps with accurate, up-to-date, and context-aware responses.
Read article → ⚡
⚡ Learn why automatic backups are essential to protect your website. Discover best practices, tools, and strategies for reliable site backup.
Read article → 📖
📖 Discover the OWASP Top 10 security risks for 2025, with concrete examples, code snippets, and actionable tips to protect your web applications.
Read article → ⚡
⚡ Master international SEO with hreflang tags and multilingual strategies. Learn how to rank globally with proven techniques and real-world examples.
Read article → 📖
📖 Discover essential clean code principles and practices to write maintainable, readable software. Concrete examples, comparisons, and expert tips inside.
Read article → 📖
📖 Learn how wireframes and mockups guide your web project from initial concept to polished design. Practical tips, tools, and real-world examples.
Read article → ⚡
⚡ Learn how to embed videos and podcasts on your website to boost engagement, SEO rankings, and conversions. Practical tips and best practices inside.
Read article → 📖
📖 Learn how remarketing and retargeting strategies can recover lost website visitors, boost conversions, and maximize your ad spend ROI.
Read article → ⚡
⚡ Learn how to measure your website ROI with proven methods, key metrics, and powerful tools. Boost your digital strategy with data-driven decisions.
Read article → 📖
📖 Learn how FOUT, FOIT and the CSS font-display property affect web performance. Practical tips, code examples, and strategies to load fonts faster.
Read article → 📖
📖 Learn how to automate technology monitoring with AI in 2025. Tools, workflows, code examples, and expert tips for smarter tech intelligence.
Read article → 📖
📖 Learn how CDNs and smart hosting strategies can dramatically accelerate your website globally. Practical tips, benchmarks, and expert insights.
Read article → ⚡
⚡ Learn how print infographics transform complex data into compelling visuals. Tips, stats, and best practices for effective data visualization.
Read article → ⚡
⚡ Discover the essential steps for SMBs to launch their digital transformation in 2025. Practical guide with concrete examples and expert tips.
Read article → ⚡
⚡ Learn how to implement dark mode on your website with CSS, JavaScript, and best practices. Boost UX, accessibility, and modern design.
Read article → 📖
📖 Learn how to execute a flawless SEO migration when changing domains or CMS. Preserve rankings, traffic, and link equity with this expert guide.
Read article → ⚡
⚡ Learn how local marketing and geomarketing help businesses target their catchment area, attract nearby customers, and boost ROI with proven strategies.
Read article → ⚡
⚡ Discover how craftsmen and small businesses can use Google Ads effectively. Learn budget tips, strategy essentials, and what results to expect.
Read article → ⚡
⚡ Discover how a monorepo strategy lets you manage multiple projects in one Git repository. Pros, cons, tools, and real-world examples inside.
Read article → 📖
📖 Learn how to build a high-performing FAQ page that boosts SEO, reduces support costs, and improves user experience. A complete 2025 guide with examples.
Read article → 📖
📖 Discover which marketing channels truly generate conversions. Learn attribution models, tools, and strategies to optimize your budget allocation.
Read article → ⚡
⚡ Learn how to design a high-availability hosting architecture that eliminates downtime. Redundancy, failover, load balancing and real-world strategies.
Read article → ⚡
⚡ Discover how AI-powered web personalization tailors content to each visitor, boosting engagement, conversions, and user experience.
Read article → 📖
📖 Learn how WAF and DDoS protection work together to defend your website from cyberattacks. Practical tips, tools, and real-world examples included.
Read article → 📖
📖 Discover how micro-interactions improve UX, boost engagement, and increase conversions. Examples, code snippets, and best practices included.
Read article → 📖
📖 Discover proven inbound marketing strategies for 2025. Learn how to attract, engage, and convert customers using content, SEO, and automation.
Read article → ⚡
⚡ Learn how the semantic cocoon strategy can transform your site architecture, improve internal linking, and dramatically boost your SEO rankings.
Read article → ⚡
⚡ Discover how executives can build authentic personal brands that drive trust, visibility, and business growth. Practical strategies and real examples inside.
Read article → 📖
📖 GraphQL vs REST API comparison: performance, flexibility, use cases. Expert guide to choosing the right architecture for your project in 2025.
Read article → ⚡
⚡ Discover how heatmaps and session recordings reveal real user behavior on your website. Boost conversions with data-driven UX insights.
Read article → 📖
📖 Discover the best AI image generation tools, practical web use cases, and best practices for quality, SEO, and legal compliance.
Read article → ⚡
⚡ Master video editing with expert tips on pacing transitions and motion graphics. Boost engagement with professional techniques that captivate viewers.
Read article → 📖
📖 Learn how to install and manage free SSL certificates with Let's Encrypt. Step-by-step guide covering Certbot, auto-renewal, and best practices.
Read article → 📖
📖 Learn how minification and bundling reduce web asset size, boost page speed, and improve SEO. Practical guide with examples, tools, and code.
Read article → ⚡
⚡ Discover how passwords, 2FA, and passkeys compare in 2025. Learn which authentication method best protects your users and your business.
Read article → ⚡
⚡ Learn the key principles of mobile UI design for touch interfaces. Practical tips, real examples, and proven strategies to boost usability and conversions.
Read article → 📖
📖 Discover how to balance evergreen and trending content for maximum SEO impact. Practical strategies, data, and examples to boost organic traffic.
Read article → 📖
📖 Learn how to analyze conversion funnels step by step, identify drop-off points, and optimize every stage of the user journey for higher ROI.
Read article → 📖
📖 Master image SEO with alt text best practices, smart file naming, compression techniques, and visual optimization tips that boost rankings and speed.
Read article → ⚡
⚡ Learn how to optimize your Nginx web server for speed and reliability. Practical tips, real configs, and benchmarks to boost performance.
Read article → 📖
📖 Learn how to protect your databases from SQL injection attacks with concrete examples, best practices, and expert security strategies.
Read article → ⚡
⚡ Learn the differences between browser cache and server cache, and discover effective caching strategies to dramatically improve your website performance.
Read article → ⚡
⚡ Learn how to implement real-time features with WebSocket in 2025. Practical guide with examples, comparisons, and best practices for live apps.
Read article → 📖
📖 Discover how color psychology impacts web design and explore the best tools to build the perfect color palette for your website.
Read article → 📖
📖 Master B2B white paper and ebook layout with this professional guide. Typography, grids, CTAs, and design best practices for lead generation.
Read article → ⚡
⚡ Learn how brand storytelling can boost engagement, trust, and conversions. Discover practical tips to craft your company narrative online.
Read article → ⚡
⚡ Learn how to install Google Tag Manager and manage all your tracking tags without writing code. A practical guide for marketers and site owners.
Read article → ⚡
⚡ Master keyword research in 2025 with proven methodology and the best free tools. Step-by-step guide to find high-value keywords for SEO.
Read article → 📖
📖 Discover how AI is reshaping SEO in 2025. Learn about Google's AI Overviews, LLM optimization, and actionable strategies to stay ahead.
Read article → 📖
📖 Step-by-step guide to migrating your website to AWS cloud hosting in 2025. Boost performance, security, and scalability with expert tips.
Read article → ⚡
⚡ Learn what XSS attacks are, why they remain a top web security threat, and how to prevent cross-site scripting on your website.
Read article → ⚡
⚡ Learn how to choose and pair web fonts like a pro. Practical tips, concrete examples, and best practices for effective web typography.
Read article → 📖
📖 Learn how to diagnose and fix slow Time to First Byte (TTFB). Actionable server-side optimizations, caching strategies, and CDN tips to boost performance.
Read article → 📖
📖 Discover how eco-responsible visual identity and sustainable design choices can reduce your brand's environmental impact while strengthening trust.
Read article → 📖
📖 Discover the essential website KPIs to track in your analytics dashboard. Boost conversions, traffic, and ROI with the right metrics.
Read article → 📖
📖 Learn how to build an editorial calendar that drives traffic, boosts SEO, and keeps your content strategy on track. Practical tips, tools, and templates.
Read article → ⚡
⚡ Shared hosting, VPS, or dedicated server? Compare performance, cost, and scalability to find the right hosting solution for your website.
Read article → 📖
📖 Master on-location filming with expert tips on managing natural light, capturing clean sound, and handling unexpected production challenges.
Read article → 📖
📖 Learn how micro-frontend architecture helps teams scale web applications. Strategies, code examples, and best practices for splitting your app.
Read article → ⚡
⚡ Discover how ChatGPT is reshaping web content creation in 2025, its real opportunities, key limitations, and how to use AI wisely for SEO.
Read article → 📖
📖 Discover the 10 most common WordPress security flaws in 2025 and learn how to protect your site with expert tips, code snippets, and best practices.
Read article → 📖
📖 Master on-page SEO in 2025 with actionable tips on title tags, content structure, Core Web Vitals, and schema markup to rank higher on Google.
Read article → 📖
📖 Discover the web design trends of 2024 that truly deliver results. From AI-driven UX to bento grids, learn what works and what's just hype.
Read article → 📖
📖 Discover how SMBs can build a winning content strategy in 2025. Actionable steps, tools, and real examples to grow your online presence.
Read article → ⚡
⚡ Learn how lazy loading images and videos can boost your site speed by 40%+. Practical guide with code examples and best practices.
Read article → ⚡
⚡ Learn how to configure conversion goals in Google Analytics 4 step by step. Boost your tracking strategy and measure what truly matters.
Read article → 📖
📖 Learn how progressive enhancement helps you build resilient, fast, and accessible websites. Practical examples, code, and expert strategies inside.
Read article → 📖
📖 Learn how to align your communication and sales teams for better prospecting results. Strategies, tools, and real-world examples included.
Read article → ⚡
⚡ Discover how roll-up banners and trade show displays boost your brand visibility at events. Tips, sizes, costs, and design best practices.
Read article → ⚡
⚡ Discover how local businesses and craftspeople can build a strong brand identity. Practical tips, real examples, and actionable steps inside.
Read article → ⚡
⚡ Discover how print finishing techniques like varnish, foil stamping, embossing, and die-cutting elevate your brand. Expert tips and comparisons inside.
Read article → ⚡
⚡ Discover the key differences between B2B and B2C communication strategies and learn how to tailor your message for maximum impact.
Read article → ⚡
⚡ Discover how logo animation and motion branding boost engagement, build trust, and make your brand unforgettable. Tips, stats, and expert insights.
Read article → ⚡
⚡ Discover how to register a trademark: step-by-step procedure, costs breakdown, and expert tips to protect your brand identity effectively.
Read article → ⚡
⚡ Learn how seasonal marketing boosts engagement and sales. Discover strategies to align your campaigns with key calendar moments.
Read article → ⚡
⚡ Offset or digital printing? Discover the key differences, cost breakdowns, and tips to choose the right method for your design project.
Read article → ⚡
⚡ Discover proven e-commerce product video filming techniques that boost conversions. Lighting, angles, demos, and tips to turn viewers into buyers.
Read article → ⚡
⚡ Discover the top logo and visual identity trends shaping 2023. From minimalism to bold typography, learn what works for modern brands.
Read article → ⚡
⚡ Discover the key KPIs and dashboards to measure communication effectiveness. Actionable tips, real examples, and tools to track your results.
Read article → 📖
📖 Discover how art direction shapes the visual identity of a campaign, from concept to execution. Key principles, tools, and real-world examples inside.
Read article → 📖
📖 Master layout grid systems for print design. Explore composition principles, grid types, and practical tips to create stunning, professional layouts.
Read article → ⚡
⚡ Learn how to plan and execute a cross-channel product launch campaign that drives awareness, engagement, and sales from day one.
Read article → 📖
📖 Learn how brand consistency across all communication channels builds trust, boosts revenue, and strengthens recognition. Actionable tips inside.
Read article → 📖
📖 Discover proven local communication strategies to boost visibility, attract nearby customers, and dominate your area with smart digital and offline tactics.
Read article → ⚡
⚡ Discover how corporate stationery — letterhead, envelope, and email signature — builds brand trust. Tips, stats, and design best practices inside.
Read article → ⚡
⚡ Discover how employer branding helps you attract and retain top talent. Practical strategies, real examples, and key metrics to build your brand.
Read article → ⚡
⚡ Learn how to define your brand tone of voice and keep it consistent across every channel. Practical steps, examples, and expert tips inside.
Read article → ⚡
⚡ Discover which referral and loyalty program mechanics truly drive retention and revenue. Real examples, proven strategies, and actionable tips.
Read article → ⚡
⚡ Learn how to launch a corporate podcast that builds brand authority. Strategy, production tips, and distribution essentials for branded podcasts.
Read article → ⚡
⚡ Discover how layout, typography, and color choices in restaurant menu design boost sales by up to 30%. Expert tips for appetizing menus.
Read article → ⚡
⚡ Discover how sonic and sensory branding strengthen brand recall. Learn why going beyond visual identity is the next competitive advantage.
Read article → ⚡
⚡ Learn how to coordinate print, digital, and events into a seamless multichannel communication strategy that boosts brand consistency and ROI.
Read article → ⚡
⚡ Stock images or custom photography? Discover when to invest in original visual content to boost your brand, SEO, and conversions.
Read article → ⚡
⚡ Discover proven packaging design strategies that boost sales. Learn how color, typography, and structure influence buying decisions.
Read article → ⚡
⚡ Discover the key logo variations every brand needs, from primary to favicon, plus usage rules to maintain consistency across all platforms.
Read article → ⚡
⚡ Discover how corporate storytelling can help you attract and convert clients. Practical tips, real examples, and strategies to craft your brand narrative.
Read article → 📖
📖 Learn how to create a compelling brand film from script to final edit. Discover the key stages, costs, and best practices for video content.
Read article → 📖
📖 Explore business signage options from office signs to vehicle wraps. Costs, ROI, design tips, and expert insights to boost your brand visibility.
Read article → 📖
📖 Discover why direct mail and print marketing are making a powerful comeback. Stats, strategies, and tips to integrate physical outreach into your digital plan.
Read article → 📖
📖 Discover why vector logo formats like AI, EPS, and SVG are essential for branding. Learn the differences, use cases, and best practices.
Read article → 📖
📖 Discover how responsible communication and genuine CSR commitments build brand authenticity, trust, and long-term customer loyalty.
Read article → ⚡
⚡ Discover drone photography regulations, professional use cases, and how aerial content elevates your brand. Expert tips for 2024 and beyond.
Read article → ⚡
⚡ Discover the golden rules of flyer and leaflet design. Learn layout tips, color choices, and typography secrets for print materials that convert.
Read article → ⚡
⚡ Discover how to choose branded merchandise and corporate gifts that recipients actually keep and use. Practical tips, stats, and real examples inside.
Read article → ⚡
⚡ Discover when and why rebranding matters. Learn the key signs it's time to evolve your visual identity and how to do it right.
Read article → ⚡
⚡ Learn how to build an annual communication plan with our free template and proven step-by-step method. Boost your brand visibility all year long.
Read article → ⚡
⚡ Learn how smart layout and data visualization transform your annual report into a powerful communication tool. Tips, examples, and best practices.
Read article → ⚡
⚡ Learn how client testimonial videos boost trust and conversions. Practical tips for capturing authentic social proof on camera.
Read article → ⚡
⚡ Learn how to build a professional brand book that ensures visual consistency and strengthens your identity. Step-by-step guide with examples.
Read article → ⚡
⚡ Discover proven strategies to organize a successful product launch event that generates buzz, engages audiences, and drives sales.
Read article → ⚡
⚡ Learn how to prepare a winning trade show booth and maximize leads. Practical tips, real stats, and expert strategies for your next event.
Read article → ⚡
⚡ Learn how to design stunning posters and banners that grab attention. Tips on resolution, typography, layout, and color for large format visuals.
Read article → ⚡
⚡ Discover the essential workflow, tools, and best practices for professional photo retouching that drives business results and brand consistency.
Read article → ⚡
⚡ Learn how to choose the right brand typography for print and digital. Expert tips on font pairing, readability, and consistency across all media.
Read article → ⚡
⚡ Discover practical, budget-friendly press relation strategies for SMEs. Learn how to earn media coverage without expensive PR agencies.
Read article → 📖
📖 Learn how PDF/X standards, bleed settings, and ICC profiles work together to produce flawless print files. A practical guide for designers and marketers.
Read article → 📖
📖 Learn how to build a consistent photographic identity that strengthens your brand. Actionable tips, examples, and frameworks for visual content strategy.
Read article → 📖
📖 Discover how color psychology shapes brand perception. Learn to choose your brand palette with intention using data, examples, and expert strategies.
Read article → ⚡
⚡ Discover how billboards, local press, and radio ads can boost foot traffic for retail businesses. Tips, costs, and ROI compared.
Read article → ⚡
⚡ Discover the key rules and latest trends in business card design. Stand out with modern layouts, materials, and branding strategies.
Read article → 📖
📖 Discover the best internal communication tools and methods to align your teams, boost engagement, and drive productivity in 2025.
Read article → ⚡
⚡ Discover why motion design is a powerful communication tool and how animated video boosts engagement, conversions, and brand awareness.
Read article → ⚡
⚡ Discover the essential elements every brand guideline document needs to be effective. Logo, typography, tone of voice, and more.
Read article → ⚡
⚡ Learn how to write a creative brief that gets results. Key sections, examples, and tips to communicate effectively with your web agency.
Read article → ⚡
⚡ Learn how to create a professional product catalog with optimized layout, efficient design workflow, and best practices that drive sales.
Read article → ⚡
⚡ Discover which corporate video formats, durations, and platforms match your business goals. A practical guide with stats and real-world examples.
Read article → ⚡
⚡ Discover the full logo redesign process, key deliverables, and realistic pricing. A practical guide to plan your rebranding project with confidence.
Read article → ⚡
⚡ Learn how to build a crisis communication plan that protects your brand reputation online. Practical steps, real examples, and expert tips.
Read article → ⚡
⚡ Learn how to design a sales brochure that converts. Practical tips on layout, copy, and print design to create brochures that drive real results.
Read article → 📖
📖 Learn how to design high-impact POS displays and merchandising materials that boost sales. Tips, examples, and digital integration strategies.
Read article → ⚡
⚡ Discover how corporate photography—team portraits and business reportage—boosts brand trust, engagement, and conversions. Practical tips inside.
Read article → ⚡
⚡ Discover proven strategies to find the perfect brand name. Tips, examples, and expert methods for memorable naming that drives business growth.
Read article → ⚡
⚡ Discover 7 common communication mistakes that hurt SME brand image and learn how to fix them to build trust and grow your business.
Read article → 📖
📖 Discover the most common print layout mistakes and proven best practices to ensure flawless professional printing every time.
Read article → 📖
📖 Learn how to build a powerful brand identity step by step — from naming and visual design to digital rollout. Practical tips, examples, and expert insights.
Read article → 📖
📖 Learn how to plan and execute a professional photo or video shoot for your brand. Step-by-step guide with checklists, budgets, and expert tips.
Read article → 📖
📖 Learn how to build a coherent communication strategy for your business. Step-by-step guide with examples, templates, and expert tips.
Read article →